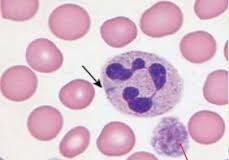

- EE. RR.
- Decreto sobre EERR
- ¿Qué son las enfermedades raras?
- Listado de enfermedades raras
- –> Vaya al listado completo de FEMEXER
- Orpha.net [ESPAÑOL]
- CIE-11 ::: Clasificación Internacional de Enfermedades (OMS)
- Listado de enfermedades raras (NIH-GARD) [EE. UU.]
- Monografías
- Catálogo Maestro de Guías de Práctica Clínica (CMGPC) [México]
- Guías de práctica médica (NIH-GARD, en inglés) [EE. UU.]
- Días dedicados a las enfermedades raras
- ¿Qué son los medicamentos huérfanos?
- Glosario de términos genéticos (NIH-GARD) [EE. UU.]
- Nosotros
- Quién y qué es FEMEXER
- FEMEXER: somos fuertes
- Misión, visión y valores
- Código de buenas prácticas en las relaciones con la industria farmacéutica
- Lo más relevante
- Los que trabajamos
- Miembros fundadores
- Los aliados invaluables de FEMEXER
- Voz de los pacientes
- Derechos de los pacientes
- Trabajo de FEMEXER
- Aliados
- Contacto
- Registro de pacientes con ER
- AcceSalud
- Palito y Toto Piden un Deseo A.C.
Consulte nuestro aviso de privacidad —2026—.
Todas las opiniones, comentarios, acciones o declaraciones (o cualquier combinación de ellas) representan únicamente la postura, visión y acción de cada uno de nuestros aliados, mas no necesariamente la de la Federación Mexicana de Enfermedades Raras (FEMEXER). De igual manera, señalamos que la federación solo es un centro de gravedad que tiene la intención de atraer las mejores causas a favor de las personas que viven con enfermedades raras. Nuestra consideración para aliar esfuerzos, en este sentido, tiene que ver con que quienes alían su esfuerzo al nuestro, lo hacen con la mejor intención de ayudar y crear condiciones que dignifiquen la vida de nuestros enfermos.
Todo el contenido de https://www.femexer.org (FEMEXER) está sujeto a los términos de la licencia Creative Commons Atribución-NoComercial-CompartirIgual 4.0 Internacional.
Todas las opiniones, comentarios, acciones o declaraciones (o cualquier combinación de ellas) representan únicamente la postura, visión y acción de cada uno de nuestros aliados, mas no necesariamente la de la Federación Mexicana de Enfermedades Raras (FEMEXER). De igual manera, señalamos que la federación solo es un centro de gravedad que tiene la intención de atraer las mejores causas a favor de las personas que viven con enfermedades raras. Nuestra consideración para aliar esfuerzos, en este sentido, tiene que ver con que quienes alían su esfuerzo al nuestro, lo hacen con la mejor intención de ayudar y crear condiciones que dignifiquen la vida de nuestros enfermos.
Todo el contenido de https://www.femexer.org (FEMEXER) está sujeto a los términos de la licencia Creative Commons Atribución-NoComercial-CompartirIgual 4.0 Internacional.